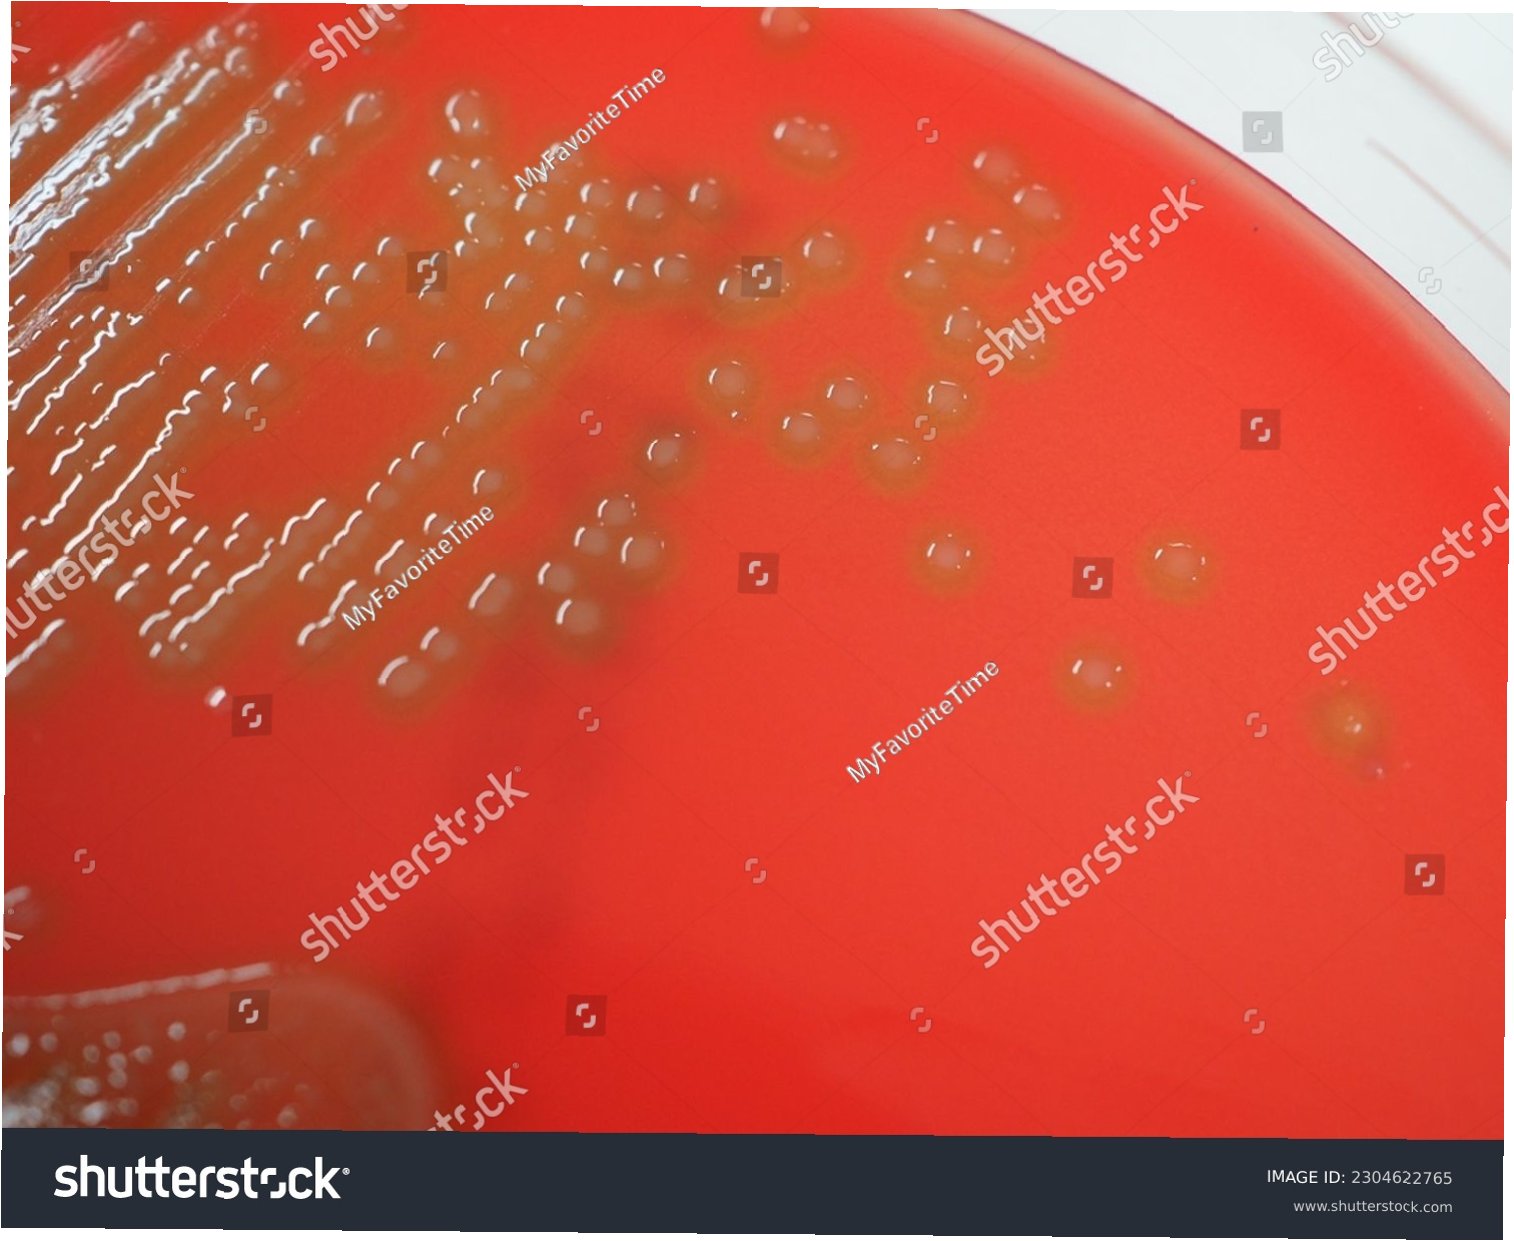

증후군일가족 8명 집단 감염, '목구멍 살인자'의 습격
대만에서 일가족 8명이 'A형 연쇄상구균'에 집단 감염되는 충격적인 사건이 발생했습니다. 8세 소년은 '목구멍이 칼에 베인 듯하다'며 극심한 통증을 호소했고, 이후 가족 7명에게도 유사한 증상이 나타났습니다. 이 중 6명은 위중한 상태로 병원 치료를 받았습니다. 장화의원은 이들이 A형 연쇄상구균에 감염되었다고 밝혔습니다. 이 균은 치명률이 최대 70%에 달하는 독성 쇼크 증후군(STSS)의 원인균으로 알려져 있습니다.

치명률 14% 이상, '살 파먹는 병'의 위험성
A형 연쇄상구균은 단순한 인후염이나 성홍열을 넘어, 혈액, 근육, 폐 등으로 침투하여 '침습성 감염'을 일으킬 수 있습니다. 이로 인해 패혈증, 괴사성 근막염, STSS, 다발성 장기부전 등 생명을 위협하는 합병증이 발생할 수 있습니다. 괴사성 근막염은 팔다리 절단으로 이어지기도 하며, STSS의 치명률은 미국 CDC에 따르면 30%에서 최대 70%에 달합니다. 국내에서도 10년간 383건의 침습성 감염 사례가 보고되었으며, 이 중 14.4%가 사망하고 11.7%는 평생 장애를 입었습니다.
국내 감염 현황 및 예방의 중요성
일본에서는 A형 연쇄상구균으로 인한 STSS 환자가 급증하고 있으며, 우리나라도 전국 단위 감시 체계가 미비한 실정입니다. 질병관리청에 따르면 국내 침습성 A군 연쇄상구균 감염 사례 중 14.4%가 사망했으며, 41.5%는 수술 또는 피부 절개술을 받았고 1.3%는 팔다리 절단에 이르렀습니다. 현재까지 백신은 개발되지 않았으므로, 조기 진단과 항생제 치료가 무엇보다 중요합니다. 인파가 모이는 장소에서 비말을 통해 쉽게 전파될 수 있으므로, 목 통증이 심할 경우 즉시 진료를 받아야 합니다.

A형 연쇄상구균, '목구멍 살인자'의 위협과 우리의 대처법
일가족 집단 감염 사례로 'A형 연쇄상구균'의 위험성이 다시 한번 부각되었습니다. 이 균은 치명적인 합병증을 유발하며, 국내에서도 상당수의 사망 및 장애 사례가 보고되었습니다. 백신이 없는 상황에서 조기 진단과 신속한 항생제 치료가 생존율을 높이는 유일한 방법입니다. 목 통증 등 의심 증상이 나타나면 즉시 의료기관을 방문하여 정확한 진단과 치료를 받아야 합니다.

A형 연쇄상구균, 이것이 궁금합니다
Q.A형 연쇄상구균은 어떻게 전파되나요?
A.주로 점막이나 피부의 상처 부위를 통해 감염되며, 환자의 비말을 통해 호흡기로도 전파될 수 있습니다. 인파가 밀집된 장소에서 감염 위험이 높아집니다.
Q.A형 연쇄상구균 감염 시 주요 증상은 무엇인가요?
A.초기에는 심한 목 통증, 인후염, 편도선 부종 등이 나타날 수 있습니다. 심해지면 패혈증, 괴사성 근막염, 독성 쇼크 증후군 등 치명적인 합병증으로 이어질 수 있습니다.
Q.A형 연쇄상구균 감염을 예방할 수 있는 백신이 있나요?
A.현재까지 A형 연쇄상구균 감염을 예방하는 백신은 개발되지 않았습니다. 따라서 개인위생 관리와 의심 증상 발생 시 신속한 진료가 중요합니다.

'이슈' 카테고리의 다른 글
| 이란 공습에 무너진 사드, '셀프 방어' 실패로 신뢰도 추락 (0) | 2026.03.15 |
|---|---|
| 이정현 위원장, 공관위원장직 복귀 선언: '모든 책임은 나에게' (0) | 2026.03.15 |
| KBO의 뼈아픈 현실: 류지현 감독, '선발 3~4명' 한계 지적하며 국제 경쟁력 강화 촉구 (0) | 2026.03.14 |
| 명동·홍대 점령한 중국 '라방'… K-패션, 길거리 라이브로 세계를 홀리다! (0) | 2026.03.14 |
| WBC 8강, 도미니카에 7회 콜드게임 완패…한국 야구의 아쉬운 성적표 (0) | 2026.03.14 |